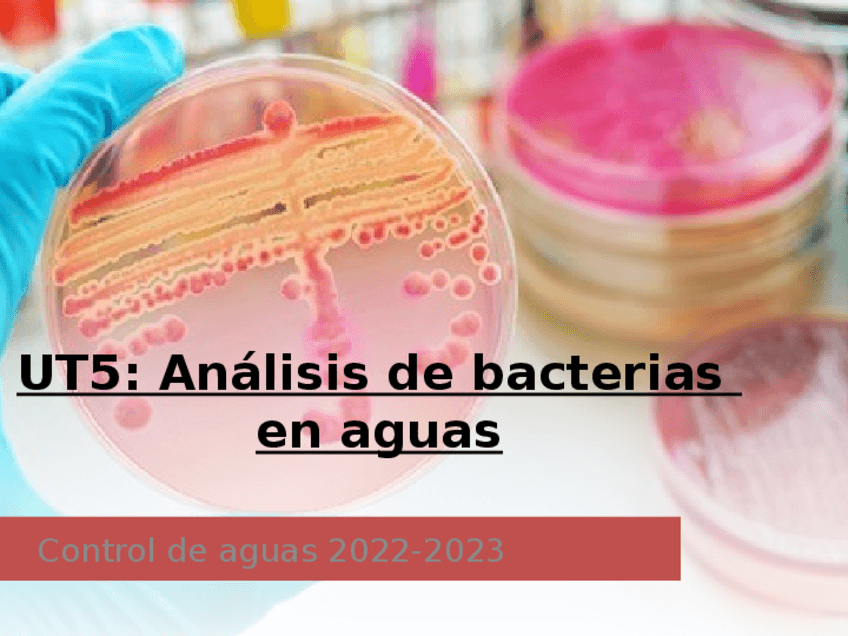

Control de Aguas
He publicado nuevos practicas de Control de Aguas: Practica-de-laboratorio-aguas-T4.docx-1-2-6.pdf
He publicado nuevos practicas de Control de Aguas: practica-de-laboratorio-aguas-T3.docx-1-1-2-6.pdf
He publicado nuevos ejercicios de Control de Aguas: Actividades-aguas-T4.docx.pdf
He publicado nuevos ejercicios de Control de Aguas: Actividades-Aguas-T3.pdf
He publicado nuevos apuntes de Control de Aguas: LES PROPIETATS DE L’AIGUA I EL CICLE DE L’AIGUA.pdf
He publicado nuevos apuntes de Control de Aguas: UT2-Evaluacion-de-las-deficiencias-tecnico-sanitarias-de-las-aguas-de-uso-y-consumo.pdf
He publicado nuevos apuntes de Control de Aguas: UT5-Toma-de-muestras-de-aguas-de-uso-y-consumo.pdf
apuntes
-
Control de aguas 1º
He publicado nuevos apuntes de Control de Aguas: Control de aguas 1º
He publicado nuevos apuntes de Control de Aguas: PRL-CONTROL-DE-AGUAS-apuntes.pdf
He publicado nuevos apuntes de Control de Aguas: Seguridad-e-higiene-en-el-laboratorio.pdf
He publicado nuevos apuntes de Control de Aguas: AGUAS DE CONSUMO Y SISTEMAS DE ABASTECIMIENTO Y PRODUCCIÓN DE AGUAS.pdf
He publicado nuevos trabajos de Control de Aguas: AGUAS-RECREATIVAS.pdf
He publicado nuevos ejercicios de Control de Aguas: Actividades-Tema-6.pdf
apuntes
-
de todo
en mi cuenta puedes ver todo, tengo las asignaturas mezcladas
He publicado nuevos trabajos de Control de Aguas: Determinacion-de-aluminio-y-sus-efectos-Agua.pptx.pdf
He publicado nuevos trabajos de Control de Aguas: Determinacion-de-cloruros.docx.pdf
examenes
-
EXAMENES TEST
He publicado nuevos examenes de Control de Aguas: EXAMENES TEST
apuntes
-
EXAMEN 8
He publicado nuevos apuntes de Control de Aguas: EXAMEN 8
apuntes
-
EXAMEN 7
He publicado nuevos apuntes de Control de Aguas: EXAMEN 7
apuntes
-
EXAMEN 6
He publicado nuevos apuntes de Control de Aguas: EXAMEN 6
apuntes
-
EXAMEN 5
He publicado nuevos apuntes de Control de Aguas: EXAMEN 5
apuntes
-
EXAMEN 4
He publicado nuevos apuntes de Control de Aguas: EXAMEN 4
apuntes
-
EXAMEN 3
He publicado nuevos apuntes de Control de Aguas: EXAMEN 3
apuntes
-
EXAMEN 2
He publicado nuevos apuntes de Control de Aguas: EXAMEN 2
apuntes
-
EXAMEN 1
He publicado nuevos apuntes de Control de Aguas: EXAMEN 1
apuntes
-
Prácticas laboratorio
He publicado nuevos apuntes de Control de Aguas: Prácticas laboratorio
practicas
-
Informe laboratorio CA
He publicado nuevos practicas de Control de Aguas: Informe laboratorio CA
apuntes
-
Teoría CA
He publicado nuevos apuntes de Control de Aguas: Teoría CA

¡Estás al día!
Has visto todos los archivos